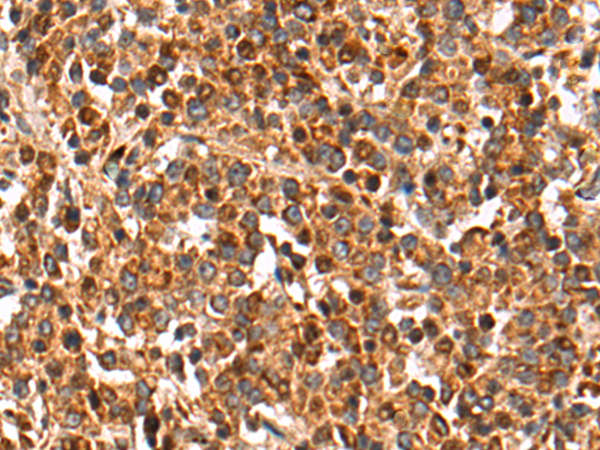
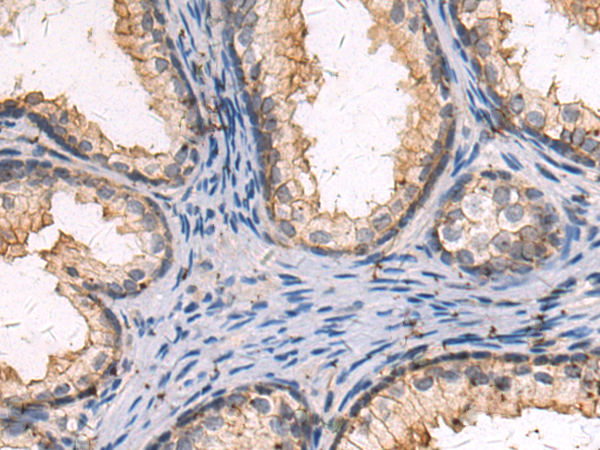
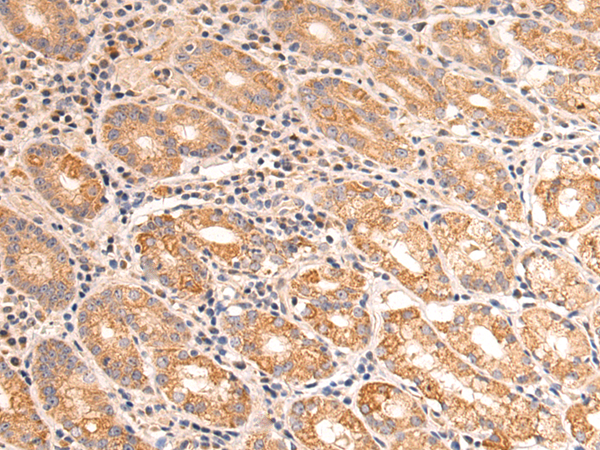
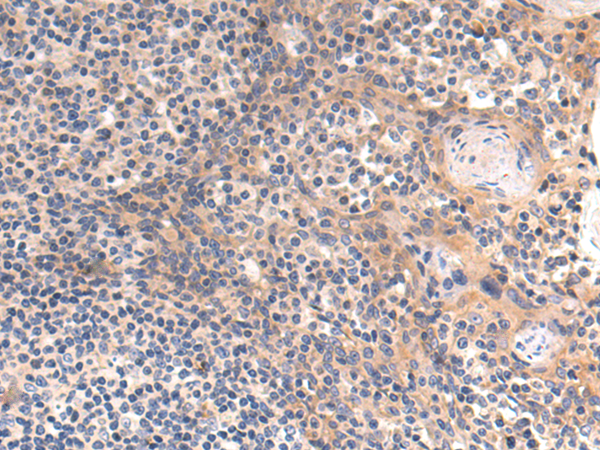

-
分类: 科研抗体货号: P10583别名: FXY2; RNF60; TRIM1; MRX101应用: IHC反应种属: Human, Mouse
-
分类: 科研抗体货号: P10582别名: XB; TNX; XBS; EDS3; HXBL; TENX; TN-X; VUR8; TNXB1; TNXB2; TNXBS; EDSCLL; EDSCLL1应用: WB,IHC反应种属: Human, Mouse
-
分类: 科研抗体货号: P10601别名: FSP1; GBP3; SPG3; HSN1D; SPG3A; AD-FSP; atlastin1应用: WB反应种属: Human, Mouse, Rat
-
分类: 科研抗体货号: P10581别名: PAL应用: WB,IHC反应种属: Human
-
分类: 科研抗体货号: P10616别名: DJ6; CT156应用: WB,IHC反应种属: Human, Mouse
-
分类: 科研抗体货号: P10600别名: FAKTS; URLC9; hFLEG1应用: IHC反应种属: Human
-
分类: 科研抗体货号: P10609别名: TRAP; CATC4; PCTAIRE2BP应用: IHC反应种属: Human, Mouse, Rat
-
分类: 科研抗体货号: P10615别名: MLC1SA应用: IHC反应种属: Human, Mouse
-
分类: 科研抗体货号: P10599别名:应用: WB,IHC反应种属: Human, Mouse, Rat
-
分类: 科研抗体货号: P10608别名: MCPH19; beta'-COP应用: IHC反应种属: Human, Mouse, Rat

鄂公网安备42018502007531号
鄂公网安备42018502007531号

